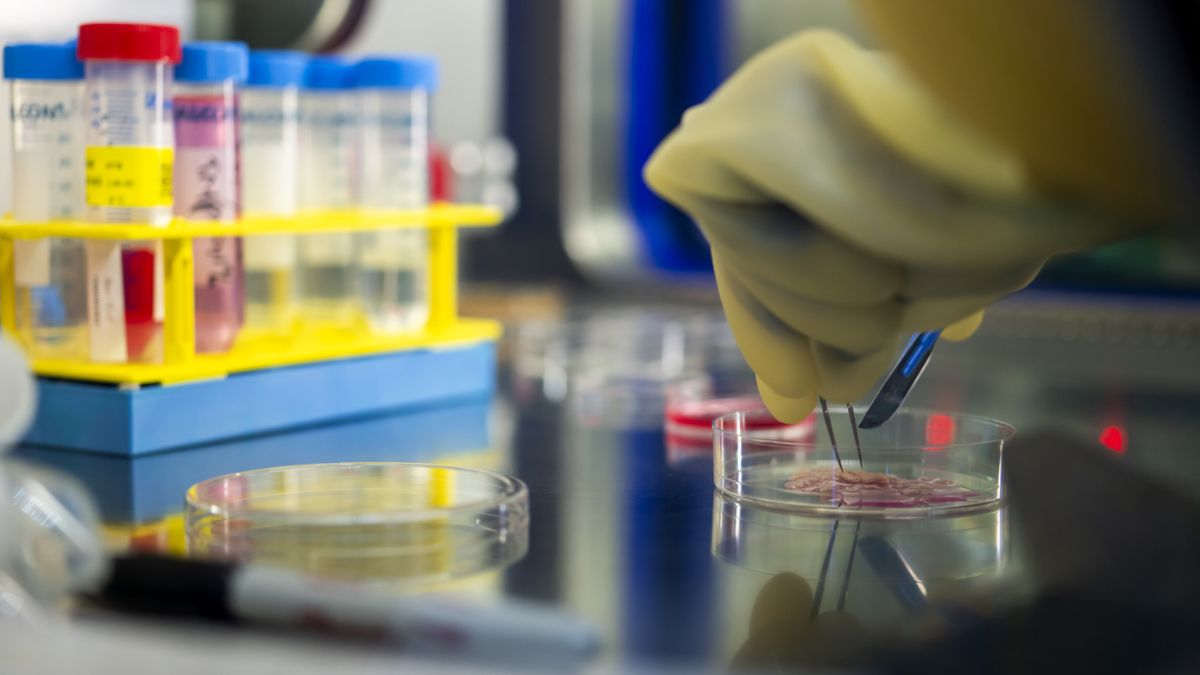

Au CHUV, une nouvelle peau fabriquée pour les grands brûlés
La fabrique de peau du CHUV, la seule en Europe de cette taille, tourne à plein régime pour aider à sauver les blessés de Crans Montana.
Après l'incendie de Crans-Montana, la fabrique de peau du centre de production cellulaire du Centre hospitalier universitaire vaudois (CHUV) tourne à plein régime pour aider à sauver les grands brûlés. Cette fabrique est la seule en Europe de cette taille.
"Il y a de l'émotion" mais "pour l'instant, on est dans l'action. La priorité, c'est d'aider au maximum ces patients", qu'ils soient hospitalisés en Suisse ou à l'étranger, déclare à l'AFP Laurent Carrez, pharmacien responsable technique pour le centre, situé dans la commune suisse d'Epalinges, dans les environs de Lausanne.
Depuis le drame de Crans-Montana, qui a fait 40 morts et 116 blessés, dont des dizaines sont encore hospitalisés, "on travaille sept jours sur sept", dit-il.
Ce centre - le seul capable de produire autant de tissu cellulaire pour la peau en respectant les législations suisse et européenne selon le CHUV - travaille avec des morceaux de peau saine prélevés sur les grands brûlés de Crans-Montana, afin d'éviter les risques de rejet.
"A partir de 10 centimètres carrés de peau saine, nous sommes capables de produire entre 1 et 3 lots de 2600 centimètres carrés. Les 2600 centimètres carrés représentent un dos à peu près en termes de surface", explique M. Carrez, qui précise que ces tissus corporels, issus de la reproduction cellulaire, ne sont toutefois pas pourvus de poils ni de glandes sudoripares.
Ce centre joue "un rôle très important" car "à partir de 50 à 60%" de surface corporelle brûlée, "on est obligé de cultiver dans des laboratoires la peau parce qu'on n'y arriverait pas simplement en utilisant la peau saine qui reste", explique le Dr Olivier Pantet, spécialiste des grands brûlés au CHUV, à l'AFP.
"Multiplication des tissus"
Dans une salle blanche, les préparateurs en pharmacie et techniciens en analyse médicale, en tenue de laboratoire, s'affairent dans le calme, autour des milieux de culture - une préparation nutritive - dans lesquelles baignent les cellules de peau pour se reproduire.
Jusqu'à présent "on a reçu les biopsies des patients. On a récupéré et stocké leurs cellules" et "on va commencer la deuxième phase, qui est la plus critique : la multiplication des tissus de kératinocytes, c'est-à-dire de peau", détaille M. Carrez.
Cette phase doit durer environ trois semaines, durant lesquelles les cellules, placées dans des boîtes, se multiplient naturellement jusqu'à ce qu'elles se touchent puis forment des strates en s'empilant les unes sur les autres.
"Puis, arrivé un moment, elles vont s'arrêter de monter, et c'est à ce moment-là qu'on sait qu'elles sont prêtes. Ça se voit aussi au niveau de l'aspect de la cellule (...) Elles ont atteint la fonction que l'on désire, c'est-à-dire leur fonction de tissu" et "sont prêtes à faire l'équivalent d'une peau", décrit M. Carrez.
Vient ensuite le travail de coordination avec les hôpitaux pour "greffer ces peaux" qui, une fois "arrivées à maturité", doivent être posées dans "les deux jours qui suivent".
Pas à 100%
La réussite de ces greffes n'est pas toujours certaine. "Si 80% des greffes prennent, on est très contents, c'est un excellent résultat", souligne le Dr Pantet du CHUV, établissement qui accueille actuellement sept grands-brûlés de Crans-Montana.
En attendant ces greffes, les médecins peuvent notamment appliquer sur les zones brûlées des pansements hermétiques, des morceaux de peau de donneurs décédés ou de peau de poisson.
D'après les premiers éléments de l'enquête, le drame a été provoqué par des étincelles de bougies "fontaine" entrées en contact avec une mousse acoustique posée au plafond du sous-sol du bar incendié.
Selon le Dr Pantet, un grand nombre des blessés de Crans-Montana ont la particularité d'être brûlés sur une grande surface mais aussi profondément.
Pour traiter ces patients grièvement brulés, le CHUV veille, étant donné leur absence de barrières cutanées, à les hydrater et au contrôle de leur température: ils sont admis dans des espaces chauffés à haute température, de l'ordre de 30 degrés, avec une humidité particulièrement élevée.
Une fois les greffes effectuées, les médecins doivent aussi veiller au positionnement des articulations pendant le processus de cicatrisation, avec notamment des attelles, avant un long processus de rééducation, explique le Dr Pantet.


